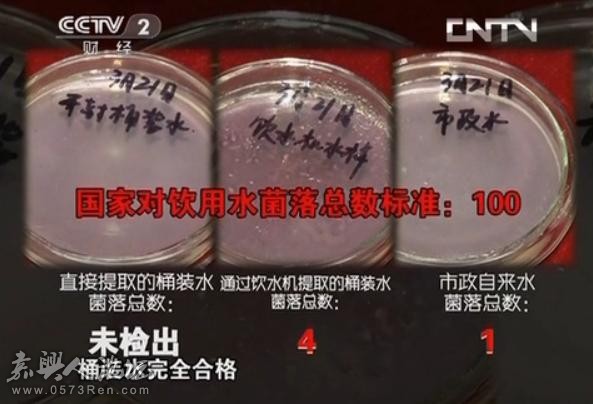
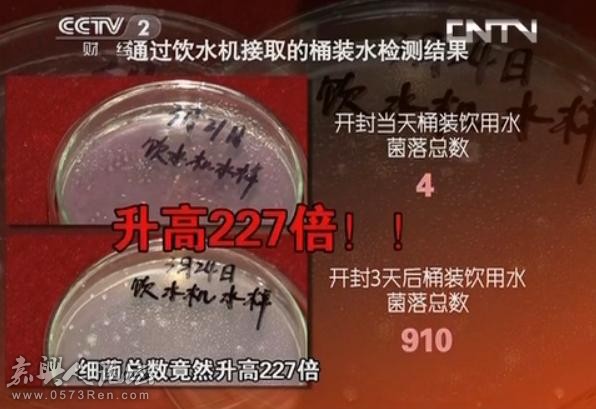

桶装水开封三天 细菌含量远远超标!

网上有传言称,桶装矿泉水开封3天后,比自来水里的细菌还要多得多,这是真的吗? 有媒体与医院人士进行了相关测验,不测不知道,一测吓一跳!
【第一道检测】
水样调取:
1、直接提取的桶装水
2、通过饮水机提取的桶装水
3、市政自来水
48小时过后,得到如下检测结果:
【第二道检测】
1、 三天后,对同样的桶装水样进行检测,从饮水机提取的桶装水检测结果如下:


2、三天后, 对同样的桶装水样进行检测,直接提取桶装水,不经过饮水机检测结果如下:
总结:同样是三天后,直接提取的桶装水与从饮水机提取的桶装水,细菌总数相差很大! 可见饮水机才是繁殖细菌的最大元凶!
专家建议:
在日常使用过程中,最好对饮水机进行清洗消毒,并且在选择时最好能选择三天后能饮用完的小容量产品。
【第三道检测】
通过饮水机提取开封三天后的桶装水前,将饮水机调到加热状态,在饮水机加热到最高温度后,从热水口接出另一瓶水样,待冷却后进行检测,检测结果表明:同样是开封三天后的桶装水,经加热后未检出菌落!

【检测总结】
1、如果按日常饮用方式,通过饮水机接出的桶装水,开封三天后的细菌含量比开封当天连翻227倍!甚至远远超过国家对饮用水细菌总量的标准; 但若对其加热烧开,细菌就会被全部杀死,再次回到安全饮用状态。

2、即使排除饮水机的污染,直接测量桶装水本身,开封三天后,细菌含量仍然超过市政自来水的菌落总量!

所以,桶装水开封三天,细菌含量远高于自来水,是真的!!!
